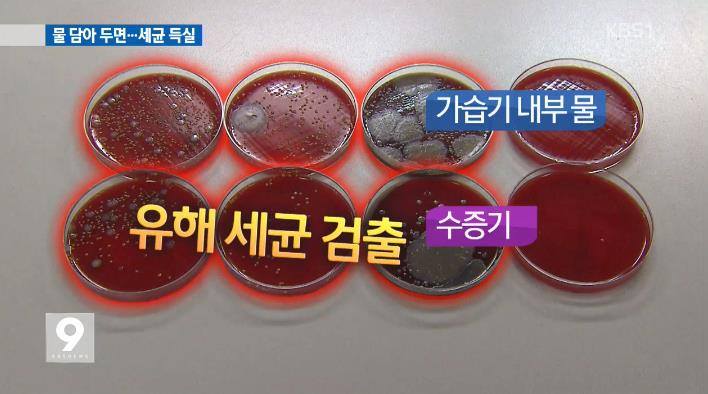

초음파가습기 vs 가열식가습기, 뭐가 더 좋을까? 장단점 세균 관리까지 완전 정리
초음파가습기 vs 가열식가습기 차이, 원리, 장단점 한 번에 비교

겨울이나 환절기만 되면 얼굴이 땅기고 목이 칼칼해지면서, 자연스럽게 가습기를 찾게 됩니다. 요즘은 피부과에서도 보습만큼이나 실내 습도 관리를 중요하게 이야기하다 보니, 가습기는 사실상 집안 필수템이 됐죠.
문제는 제품을 고를 때입니다. 초음파가습기가 좋다는 말도, 가열식가습기가 더 안전하다는 말도 있어서 헷갈리기 마련이에요. 여기에 자연 기화식 가습기까지 더해지면 머리가 더 복잡해집니다.
이 글에서는 초음파가습기 vs 가열식가습기 차이는 물론, 자연 기화식 가습기까지 함께 비교하고, 마지막에는 가습기 세균 번식 막는법·청소법까지 이어서 정리해 볼게요.
가습기 종류 한눈에 보기 – 초음파식 / 가열식 / 자연 기화식
가습기는 기본적으로 공기 중에 물 입자나 수증기를 뿌려서 습도를 올리는 기계입니다. 방식에 따라 크게 세 가지로 나뉘어요.
- 초음파식 가습기 – 초음파 진동으로 물을 잘게 부숴 물안개처럼 내보내는 방식
- 가열식 가습기 – 물을 끓여서 뜨거운 수증기를 내보내는 방식
- 자연 기화식 가습기 – 젖은 필터에 바람을 불어 자연스럽게 증발시키는 방식
| 가습기 종류 | 작동 원리 | 장점 | 단점 |
| 초음파식 | 초음파 진동으로 물을 미세 물방울로 분무 | 가격이 저렴함 소음이 적고 전력 소모가 낮음 |
물에 있는 세균·불순물이 함께 분사될 수 있음 분무가 무거워 주변 바닥이 젖기 쉬움 |
| 가열식 | 물을 끓여 수증기 상태로 분출 | 끓이면서 많은 세균이 사멸 따뜻한 수증기로 약간의 난방 효과 |
소비전력이 높은 편 가열 부위에 석회·광물질이 잘 달라붙음 |
| 자연 기화식 | 젖은 필터에 바람을 보내 자연 증발 유도 | 과습 가능성이 낮고 공기 정화 효과 기대 분무가 눈에 보이지 않아 부담이 적음 |
제품 가격이 높은 편 필터 등 소모품 교체 비용 발생 |
어떤 가습기가 “정답”이라고 말할 수는 없고, 예산·전기요금·청소 귀찮음 정도·아이 유무에 따라 어울리는 타입이 달라집니다. 아래에서 하나씩 조금 더 깊게 볼게요.
초음파가습기 특징 – 조용하고 저렴하지만, 물 관리가 핵심

초음파가습기는 물통 바닥에 있는 진동자가 초음파로 고속 진동하면서 물을 잘게 쪼개 흰 안개처럼 분무하는 방식입니다. 구조가 단순해서 가격이 비교적 저렴하고, 작은 미니 가습기부터 대용량까지 종류가 정말 다양해요.
초음파가습기 장점
1. 가격이 상대적으로 저렴해 처음 입문용으로 쓰기 좋다.
2. 팬 소리만 조금 들릴 정도라 수면 중에도 쾌적한 편이다.
3. 가열을 하지 않기 때문에 전기 사용량이 적고 전기요금 부담이 적다.
4. 작은 탁상용 제품도 많아서 사무실·원룸 책상 위에 두고 쓰기 편하다.
초음파가습기 단점 & 주의할 점
1. 물 속에 있던 세균, 곰팡이, 미네랄 성분이 그대로 공기 중으로 분무될 수 있다.
2. 물 입자가 비교적 무거워 주변 바닥이나 가구가 축축해지기 쉽다.
3. 관리가 소홀하면 분사되는 물안개에서 하얀 가루, 냄새가 날 수 있다.
그래서 초음파가습기를 쓸 때는 “얼마나 자주 물을 갈고 청소하느냐”가 성능만큼이나 중요합니다. 물을 오래 방치한 초음파가습기는 말 그대로 세균 분무기가 될 수 있어요.
가열식가습기 특징 – 따뜻하고 깨끗하지만, 전기요금·소음 체크

가열식가습기는 전기 히터로 물을 끓여 진짜 수증기를 내보내는 방식입니다. 전통적인 주전자 끓이기랑 원리는 크게 다르지 않아요. 물을 끓이면서 많은 세균이 함께 사라지기 때문에, 위생 면에서 상대적으로 안심할 수 있다는 점이 가장 큰 매력입니다.
가열식가습기 장점
1. 물을 끓여 사용하므로 세균 번식 걱정이 상대적으로 적다.
2. 따뜻한 수증기가 나와서 겨울에 체감 온도가 약간 올라가는 느낌을 준다.
3. 초음파 분무처럼 물방울이 바닥에 떨어지지 않아 가구나 바닥이 덜 젖는다.
가열식가습기 단점
1. 물을 끓이는 구조라 전기 사용량이 많고 전기요금 부담이 생길 수 있다.
2. 물이 끓는 소리, 히터 작동 소리 등으로 조용한 밤에는 소음이 거슬릴 수 있다.
3. 가열판 주변에 석회·광물질이 달라붙어 정기적인 세척이 꼭 필요하다.
4. 뜨거운 물이 들어 있으므로 아이·반려동물 있는 집에서는 넘어지지 않게 위치 선정을 신경 써야 한다.
자연 기화식 가습기 특징 – 공기청정기 느낌의 부드러운 가습

자연 기화식 가습기는 이름 그대로 자연스럽게 증발되도록 도와주는 타입입니다. 물에 적신 필터에 바람을 보내, 마치 빨래가 마르듯 천천히 공기 중으로 수분이 날아가도록 만드는 구조예요.
자연 기화식 가습기 장점
1. 공기 중 습도가 높아지면 증발 속도가 자연스럽게 줄어들어 과습 걱정이 적다.
2. 분무가 눈에 보이는 형태가 아니라 벽이나 바닥이 젖을 일이 적다.
3. 필터가 일종의 간이 공기 정화 기능을 하기도 해서 먼지·이물질 감소에 도움이 될 수 있다.
자연 기화식 가습기 단점
1. 초음파식에 비해 제품 가격이 높은 편인 경우가 많다.
2. 필터 교체 등 소모품 비용이 추가로 들어간다.
3. 수조 안에는 여전히 물이 있기 때문에 정기적인 물 교체와 세척은 필수다.

정리하자면,
- 초음파가습기 – 저렴하고 조용하지만, 물 관리 잘 해야 함
- 가열식가습기 – 따뜻하고 위생적이지만, 전기요금·소음 감수
- 자연 기화식 가습기 – 부드럽고 과습 적지만, 가격·필터 비용 고려
집 구조, 가족 구성, 예산을 생각해 보고 여기에 “내가 얼마나 부지런히 청소할 수 있는지”까지 함께 고려하면, 나와 잘 맞는 가습기 타입을 고르기 훨씬 쉬워집니다.
가습기 청소 세척방법 - 세제 사용없이 청소방법
가습기 종류에 상관없이, 제대로 된 청소 습관이 안전한 가습의 핵심입니다.
jab-guyver.co.kr
가습기 세균 번식 막는 방법 & 안전한 청소 습관

가습기는 잘 쓰면 호흡기·피부 건강에 도움이 되지만, 관리가 엉망이면 실내에 미생물을 뿜는 기계가 될 수 있습니다. 물이 항상 고여 있는 구조라서 세균·곰팡이가 자라기 딱 좋은 환경이거든요.
특히 초음파가습기처럼 물방울을 그대로 빵빵 뿜는 제품은, 내부 물 상태에 따라 공기 질이 천국이 될 수도, 지옥이 될 수도 있습니다. 아래 기본 수칙만 지켜도 위험도를 크게 줄일 수 있어요.
가습기 물은 매일 교체 + 최소 이틀에 한 번 청소
가습기 물통은 하루만 지나도 미생물이 훌쩍 늘어나는 환경입니다. 그래서:
- 물은 매일 갈아주고 남은 물은 비우기
- 적어도 이틀에 한 번은 내부를 가볍게 세척해 주기
- 일주일에 한 번 정도는 조금 더 꼼꼼한 청소 해주기
특히 노인, 아이, 임산부, 비염·천식 환자가 있는 집이라면 물 교체와 청소 주기를 더 짧게 가져가는 편이 좋습니다.
가습기 청소 – 베이킹소다·식초·소금 활용하기

세제를 쓰면 편하긴 하지만, 세제 찌꺼기가 남을까 걱정될 때가 많죠. 이때 베이킹소다·식초·소금 조합이 꽤 유용합니다.
- 물통과 내부는 베이킹소다 + 미지근한 물로 문질러 세척
- 가열판·석회 침전물은 식초를 섞은 물에 잠깐 담갔다가 부드럽게 닦기
- 냄새가 심할 때는 소량의 소금을 활용해 살짝 문질러 준 뒤 충분히 헹구기
세제를 사용했다면, 여러 번 헹궈서 거품·냄새가 완전히 사라질 때까지 세척해 주세요. 청소 후에는 물기를 잘 털어낸 뒤, 가능하면 햇볕이 드는 곳에서 충분히 말린 뒤 사용하는 것이 좋습니다. 필터가 있는 제품은 3~6개월마다 교체 주기를 체크해 주세요.
가습기와의 거리·사용 시간·환기
가습기를 바로 코 앞에 두고 쓰면 왠지 더 촉촉해질 것 같지만, 오히려 점막을 자극할 수 있습니다.
- 가습기는 최소 2m 이상 떨어진 곳에 두기
- 한 번 켜면 연속 3시간 이상 오래 틀지 않기 (상황에 따라 조절)
- 하루에 2번 이상 창문을 열어 환기하기
실내를 꽉 닫은 채로 가습기만 오래 틀면, 공기 중 습도는 올라가는데 산소 농도는 떨어지고 곰팡이·세균 번식이 오히려 더 잘 되는 환경이 만들어집니다. 촉촉함도 중요하지만, 신선한 공기가 먼저예요.
가습기 대신 쓸 수 있는 습도 유지 방법


가습기를 쓸 수 없는 상황이라면, 이런 방법으로도 실내 습도를 조금씩 올릴 수 있습니다.
- 실내에 화분·공기정화 식물 두기
- 샤워 후 욕실 문을 열어 수증기가 방으로 자연스럽게 퍼지게 하기
- 깨끗하게 씻은 귤껍질이나 축축한 수건을 방 안에 걸어두기
- 숯·토기 같은 천연 재료로 미세한 습도 조절하기
물은 정수기 물보다 수돗물을 권장하는 경우가 많은데, 이는 정수기 안에서 오래 머문 물에 오히려 미생물이 많을 수 있기 때문입니다. 이 부분은 사용하는 정수기 관리 상태에 따라 달라지니, 평소 관리 상태를 한 번 점검해 보세요.

가습기에서 추출한 샘플의 상당수에서 곰팡이·박테리아가 발견됐다는 조사 결과들도 있습니다. 그래서 요즘은 열탕 소독이 가능한 제품을 찾는 분들도 많고, 어떤 제품이든 매일 물 교체 + 정기적인 열탕·식초 세척만 잘 지켜도 위험을 크게 줄일 수 있습니다.
실제로 조사 결과, 사용 중인 가습기 물통 상당수에서 곰팡이와 병원성 세균이 검출된 적이 있습니다. 그렇다고 가습기를 무조건 두려워할 필요는 없고, 청소와 환기, 물 교체만 잘 지키면 충분히 안전하게 사용할 수 있습니다.
가습기 청소 세척방법 - 세제 사용없이 청소방법
안전한 가습기를 위해서는 정기적인 세척과 올바른 사용 습관이 가장 중요합니다.
jab-guyver.co.kr
FAQ – 초음파가습기 vs 가열식가습기, 그리고 가습기 관리
Q: 아기가 있는 집에는 초음파가습기랑 가열식가습기 중 뭐가 더 나을까요?
A: 둘 다 쓸 수 있지만, 청소를 얼마나 자주 하느냐가 더 중요합니다. 초음파가습기는 물 상태에 민감해서 물 교체·세척을 잘할 수 있다면 편하고 좋고, 일이 많아 관리에 자신이 없다면 가열식이나 자연 기화식 쪽이 마음이 편할 수 있어요.
Q: 가습기에 생수나 정수기 물을 써도 되나요?
A: 물 종류보다는 얼마나 자주 갈아주는지가 더 중요합니다. 생수나 정수기 물도 오래 놔두면 미생물이 늘어날 수 있어요. 어떤 물을 쓰든 매일 갈아주는 것을 우선으로 생각하시면 됩니다.
Q: 가습기를 밤새 켜 두는 건 괜찮나요?
A: 사람마다 다르지만, 일반적으로는 과습만 조심하면 됩니다. 가습량이 많은 제품이라면 타이머 기능을 활용하거나 약하게 틀어두는 편이 좋고, 자고 일어나서 방이 축축하다 느껴진다면 가습 시간을 줄이거나 위치를 조정해 보는 게 좋아요.
Q: 냄새가 조금 나는 초음파가습기를 그냥 써도 되나요?
A: 안 됩니다. 냄새가 난다는 건 이미 내부에 세균·곰팡이가 많이 자랐다는 신호일 가능성이 높습니다. 즉시 사용을 멈추고, 물을 모두 비우고, 베이킹소다·식초 등으로 꼼꼼하게 청소한 뒤 다시 써야 합니다. 그래도 냄새가 계속 나면 과감히 교체를 고민하는 게 안전해요.
Q: 필터 교체 알림이 없는데, 언제 갈아야 할지 모르겠어요.
A: 대부분의 자연 기화식·일부 가열식 가습기는 설명서에 권장 교체 주기(예: 3~6개월)가 적혀 있습니다. 사용량이 많거나 물때·냄새가 심해지면, 기간이 안 됐더라도 조금 더 빨리 교체해 주는 게 좋습니다.
Q: 겨울 피부가 너무 건조한데, 가습기만 틀어도 좋아질까요?
A: 가습기는 기본 환경을 만들어주는 역할이라 생각하면 편합니다. 실내 습도를 적절하게 유지해 주면 피부가 덜 당기고, 보습제 효과도 더 잘 살아나요. 여기에 보습제·수분 섭취·가습기 청소까지 함께 챙기면 훨씬 확실한 변화를 느낄 수 있습니다.